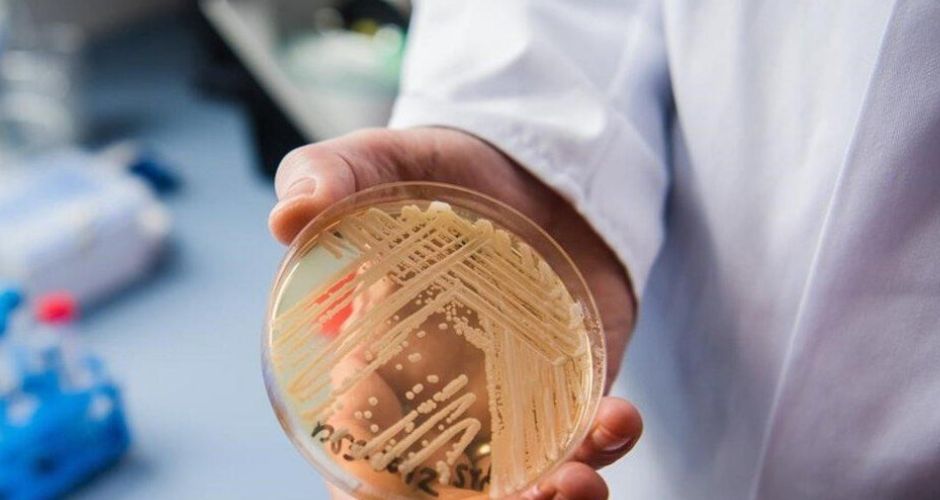

El Centro Europeo para la Prevención y Control de Enfermedades (ECDC) advierte del rápido avance del hongo ‘candida auris’ en hospitales del continente. Y España se sitúa a la cabeza: de los más de 4.000 casos notificados en la última década, 1.807 corresponden a nuestro país.
Se trata de «hongos oportunistas y se aprovechan fundamentalmente de las personas que están ingresadas en los hospitales», afirma Raúl Ortiz de Lejarazu y Leonardo, Doctor en Medicina, Microbiología Médica y Bacteriana. Provoca infecciones invasivas en la sangre, la piel o los pulmones y, en algunos casos, puede causar la muerte.
El hongo es multirresistente a los tratamientos convencionales y se propaga con facilidad porque sobrevive en superficies hospitalarias. «Lo que preocupa más es la infección sistémica, y esa realmente en muchos de los casos es mortal», asegura el microbiólogo Raúl Ortiz de Lejarazu.
Entre 2013 y 2023, Grecia (852 casos), Italia (712), Rumanía (404) y Alemania (120) se suman a España como los países más afectados. La transmisión local sostenida se ha disparado en solo unos años, y algunos países ya reconocen que no pueden distinguir brotes específicos por la extensión regional.
«C.Auris ha pasado de casos aislados a una propagación generalizada en muy poco tiempo. Eso demuestra la rapidez con la que puede establecerse en los hospitales», advierte Diamantis Plachouras, jefe de la Sección de Resistencia de Antimicrobianos del ECDC. El organismo reclama medidas urgentes: detección temprana, control coordinado de infecciones y sistemas de vigilancia eficaces. Hoy solo 17 de los 36 países europeos cuentan con una red nacional de seguimiento de este hongo y apenas 15 tienen protocolos de prevención específicos.
Mientras, los expertos recuerdan las claves: afecta sobre todo a enfermos crónicos, pacientes con cáncer o diabetes, y puede multiplicar su impacto si no se corta cuanto antes.